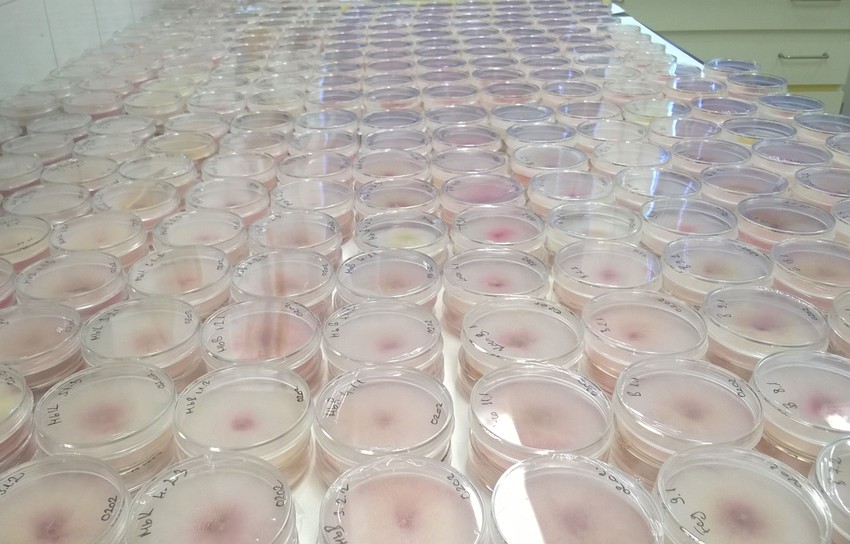
Fusarium izolátumok laboratóriumban

A fuzárium a mezőgazdaságban az egyik legelterjedtebb mikroszkopikus gombafajta, amely megfertőzi a haszonnövényeinket, különösen a kalászos gabonákat, és az általa termelt toxinok komoly betegségeket okozhatnak.
Mérlegelni kell, hogy toxinnal szennyezett, vagy növényvédelmi kezelésen átesett gabonából készült pékáru elfogyasztása a veszélyesebb számunkra.
Egészségre ártalmatlan gombaölő szerekkel és rezisztencia-nemesítéssel harcolhatunk a fuzárium ellen a mezőgazdaságban
A fuzárium a mezőgazdaságban az egyik legelterjedtebb mikroszkopikus gombafajta, amely a fenntartható gazdálkodás ellenségeként megfertőzi a haszonnövényeinket, különösen a kalászos gabonákat, és az általa termelt toxinok komoly betegségeket okozhatnak. Dr. Tóth Beáta, a NAIK Növénytermesztési Önálló Kutatási Osztály tudományos főmunkatársa szerint 2019-ben a fuzárium szempontjából veszélyes évre számíthatunk. A fuzárium elleni átgondolt védekezéssel hozzájárulhatunk a fenntartható gazdálkodáshoz.
A fuzárium egy fonalasgomba, amely a mezőgazdaságban dolgozó gabonatermesztők között jól ismert gombanemzetség tagja, és amelybe hozzávetőlegesen ezer faj tartozik. Ezek közül számos faj jelentős élettani hatású anyagokat, úgynevezett mikotoxinokat termel, amivel a fenntartható gazdálkodás egyik nagy ellenségeivé váltak. A mikotoxinok a természetben, és egyben a mezőgazdaságban előforduló legveszélyesebb méreganyagok közé tartoznak.
A mikotoxint termelő Fusarium fajok elsősorban a talajban található növényi maradványokon telelnek át, innen támadják meg az élő növényi szervezeteket, majd a gombák a gabonaszem külső felületén megkezdik a fertőzési folyamatot, amivel hatalmas kárt okoznak a fenntartható gazdálkodás mellett elkötelezett gazdáknak.
„Magyarország változékony éghajlata miatt aszályos és csapadékos évben egyaránt fennáll a kockázat, hogy fuzáriummal szennyezett lesz a termény. Ennek oka, hogy a kórokozó gombák között mind a száraz, mind pedig a nedves éghajlatot kedvelő fajok megtalálhatóak. A talajból fertőző fuzáriummal szembeni egyik lehetséges védekezés a mezőgazdaságban a magcsávázás. Ezzel a technológiával a vetőmag teljes felületét bevonják már a vetés előtt egy olyan növényvédő szerrel, amellyel megfelelő védelmet biztosít a talajból fertőző gombákkal – köztük a fuzáriummal – szemben is.
Nagyobb problémát jelentenek azonban a különböző kultúrák virágzási stádiumában fellépő fuzárium fertőzések, amelyek ellen megfelelő gombaölő készítmények kijuttatásával lehet eredményesen fellépni a mezőgazdaságban. Emellett azonban bizonyos esetekben a fuzárium kialakulásához a rovarkártevők által okozott sebzések is hozzájárulnak, éppen ezért a védekezési technológia részét képzi a megfelelő rovarölő készítmény használata is. Csak így lehetünk biztosak abban, hogy mindent megtettünk a fenntartható gazdálkodás megmaradásáért” – mondta Fogl Tamás, a Bayer Hungária Kft. fejlesztési menedzsere.

Fuzáriummal mesterségesen fertőzött gabona
Forrás: NAIK
A növénynemesítés a megoldás?
A fuzárium kialakulására fokozottan hajlamosít a gomba számára kedvező időjárás, valamint a stresszes, legyengült növényállomány. A fenntartható gazdálkodás iránt elkötelezett szakemberek előtt ezért nagy kihívás áll.
„Ezért van szükséges a növénynemesítésre, hogy a fuzáriummal szemben minél ellenállóbb gabonákat nemesítsenek ki a szakemberek. Bár a nemesítők részéről a munka folyamatos, és vannak biztató eredmények, azonban egyelőre a több évtizedes kutatások ellenére sem ismeretes olyan gabonafajta a mezőgazdaságban, ami teljesen ellenálló lenne ezekkel a gombafajokkal szemben. Nagyon nehéz egy gabonafajtába az összes kiváló tulajdonságot egybegyűjteni, azaz legyen ellenálló a különböző betegségekkel szemben, alkalmazkodjon az adott klímához, emellett pedig megfelelő termésátlagot is hozzon” – mutatott rá Fogl Tamás.
A szakember szerint a fenntartható gazdálkodás fenntartásához jelen pillanatban hatékony módszer a gombaölőszer használata:
„Én a komplex védekezést ajánlom a mezőgazdaságban dolgozó gazdáknak, hogy vetéskor használjanak magcsávázó készítményeket, virágzáskor pedig olyan szereket, amelyek hatékonyak a gabonát fertőző fuzárium fajok ellen. A csávázószerek hatástartalma nyilvánvalóan nem terjed ki a tavaszi időszakban fellépő gombafertőzésekre, ezért szükséges a legalább egyszeri kezelés tavasz folyamán a különböző levélbetegségekkel szemben éppúgy, mint virágzás alatt célzottan a fuzárium ellen” – tanácsolja Fogl Tamás szakértő.

Kalászos kórtani tenyészkert
Forrás: NAIK
A fuzárium az egészségre is veszélyes
A fuzárium gomba ellen a mezőgazdaságban régóta alkalmazott eljárás volt, hogy vetésforgóban művelték a földet: ha egyik évben gabona termett a területen, a következő években más terményt vetettek oda, így a gomba kitartóképletei nehezebben maradtak fenn a növényi maradványokon az adott területen. Ezen módszer sokat segített a fenntartható gazdálkodás megteremtésében. Manapság azonban a vetésforgó beszűkült, ami azt jelenti, hogy rövidebb idő alatt kerülnek vissza ugyanazok a kultúrák a mezőgazdaságban egyazon területre.
Ehhez pluszban hozzájárul az is, hogy a föld megművelésének formája is változik. A szántásos (forgatásos) talajművelés egyre inkább lecserélődik a forgatás nélküli művelésre, ahol az előbb említett növényi maradványokat nem tudják teljes mértékben a talajba dolgozni, ezzel kiváló táptalajt hagyva a föld felszínén maradt növényi maradványokon a fuzárium kitartóképleteinek a következő évben a fertőzéshez. Természetesen ebben az esetben a fenntartható gazdálkodás jegyében fokozottabban kell védekezni az összes gombabetegség ellen is.
A fuzáriummal szembeni, nem megfelelő védekezés komoly hatással lehet az emberi egészségre is. A mikotoxin szélsőséges esetben súlyos máj-, vagy vesekárosodást, de akár daganatos megbetegedéseket is okozhat, miközben nagy veszélyt jelent a fenntartható gazdálkodásra is.
„Mérlegelnünk kell, hogy egészségünk szempontjából mivel veszítünk többet. Egy toxinnal szennyezett kenyér, vagy egy növényvédelmi kezelésen átesett gabonából készült pékáru elfogyasztása a veszélyesebb számunkra? Utóbbi esetben előfordulhat, hogy minimális mennyiségű szermaradék megtalálható a gabonán, ám ez a technológia előírásait betartva, mindig az engedélyezett határérték alatt marad, amelynek semmiféle, az emberi egészségre gyakorolt hatása nincsen. Az előállítást ezzel párhuzamosan szigorúan ellenőrzik a szakhatóságok. Így egészségünk szempontjából lényegesen kedvezőbb, ha toxinmentes élelmiszereket tudunk előállítani és fogyasztani a toxinnal szennyezett termékek helyett!„ – nyomatékosította Fogl Tamás.
Fusarium izolátumok laboratóriumban
Forrás: NAIK
Idén ismét megnövekedhet a fuzárium okozta fertőzés
Dr. Tóth Beáta, a NAIK Növénytermesztési Önálló Kutatási Osztály tudományos főmunkatársa szerint fuzárium szempontjából kockázatosnak mondható az idei év, hiszen májusban országszerte egy napon belül egymást követték a meleg, napsütéses és a rendkívül csapadékos órák – a meleg és párás időjárás pedig igen kedvező a fuzáriumok szaporodásához a mezőgazdaságban.
A NAIK Növénytermesztési Önálló Kutatási Osztálya a szegedi Gabonakutatóban végez rezisztencia-kutatási kísérleteket. Egyik fő céljuk, hogy a jó terméshozam mellett, a kalászosok minél ellenállóbbak legyenek a fuzáriummal szemben. Munkájuk és előremutató kísérleteik segítik a fenntartható gazdálkodást is. Dr. Tóth Beáta évek óta részt vesz az őszi búza kalászfuzáriummal szembeni rezisztencia-nemesítésében.
„A két utolsó jelentősebb fuzárium járvány 2010-ben és 2015-ben söpört végig Magyarországon. A fuzárium minden kalászosra veszélyt jelent a mezőgazdaságban. Az ősi gabonák bizonyos típusai ellenállóbbak, amiben a kalász morfológiai adottságai is szerepet játszanak. Ha egy kalász tömöttebb, vagy hosszabb szálkái vannak, könnyebben fertőződik meg. Idén is járványos évre számítunk, és sajnos a fuzárium felbukkanásáról szóló első jelentések már be is futottak hozzánk. Mivel szerencsére nem minden esztendőben van járvány, ezért szükséges a nemesítési törzsek, fajtajelöltek, fajták mesterséges fertőzési kísérletekben történő vizsgálata. Ilyenkor egy kórtani tenyészkertben a búza virágzásakor gombaszuszpenziót juttatunk a virágzó kalászok felszínére, majd a tünetek vizuális felvételezése mellett mérjük a fertőzött minták DON toxin tartalmát. Ezzel a célunk az, hogy minden évben tesztelni tudjuk a kalászos genotípusok ellenállóságát, és ne csak a járványos esztendőkben álljon rendelkezésünkre ellenállósági adat. A nemesítési folyamat ugyanis évekig tart. Az állami bejelentés előtt álló, már fejlett törzseket legalább három évig vizsgáljuk. A NÉBIH-hez való bejelentés után újabb hároméves vizsgálat következik. A többéves vizsgálat alapján, meg tudjuk adni egy skálán az egyes új fajták fuzáriummal szembeni ellenállósági szintjét„ – fejtette ki a szakember.
Így süthet egészséges kenyeret otthon!
A '70-es évek óta kutatják az ellenszert
Dr. Tóth Beáta nem győzi hangsúlyozni, hogy a nemesítés a kalászosoknál is egy rendkívül összetett folyamat. Amikor egy olyan fajtát találnak, ami a fuzáriummal szemben a többinél jóval ellenállóbb, még nem nyugodhatnak meg. Ha ez a fajta nem hozza az elvárt hozamot, vagy lényegesen rosszabbul viseli a szárazságot, nem sikerült a kívánt célt elérni a kutatóknak és a fajta nem jelenik meg a mezőgazdaságban.
„Rezisztencia-nemesítés esetén mindig arra törekszünk, hogy a fuzárium-ellenállóság mellett a kalászosokat megtámadó többi gombával szembeni ellenállóságot is erősítsük. A fuzárium-ellenállósággal kapcsolatos kutatások már az 1970-es években megkezdődtek, és vannak biztató eredményeink, azonban egyelőre a fenntartható gazdálkodás érdekében a növényvédőszeres kezelést nem szabad kihagyni a gazdáknak. Célunk, hogy a fuzáriummal szembeni ellenállóképesség növelésével egy idő után csökkenjen a fungicidek (gombaölő szerek) használata, de jelen állás szerint ezt teljesen elhagyni a mezőgazdaságban a jövőben sem szabad. A jövő a precíziós gazdálkodásé, amely többek között abban is segít a gazdáknak, hogy meghatározza, hogy a termőföldjükön mekkora területen, egy táblán belül pontosan hova, és milyen mennyiségben kell kibocsátaniuk a növényvédő szereket. A precíziós mezőgazdaság és a fuzáriummal szembeni ellenállóság növelése kéz a kézben járnak, ami végső soron mind a fungicidek használatának csökkentéséhez és a fenntartható gazdálkodás sikeréhez járul hozzá” – mondta Dr. Tóth Beáta.
Magyarországon elsősorban a Fusarium graminearum-ot tartják felelősnek a kalászosok fertőzéséért, de a gombanemzetség más fajai is képesek mikotoxint termelni. Jó hír azonban, hogy ha a Fusarium graminearum-mal szemben megtalálják a legellenállóbb kalászos gabonát, az a többi fuzárium gombafajtának is ugyanolyan hatékonysággal áll majd ellen, ami nagyban segíti majd a fenntartható gazdálkodást.
Forrás: NAIK Növénytermesztési Önálló Kutatási Osztály
Kövesse az Egészségkalauz cikkeit a Google Hírek-ben, a Facebook-on, az Instagramon vagy a X-en,Tiktok-on is!









